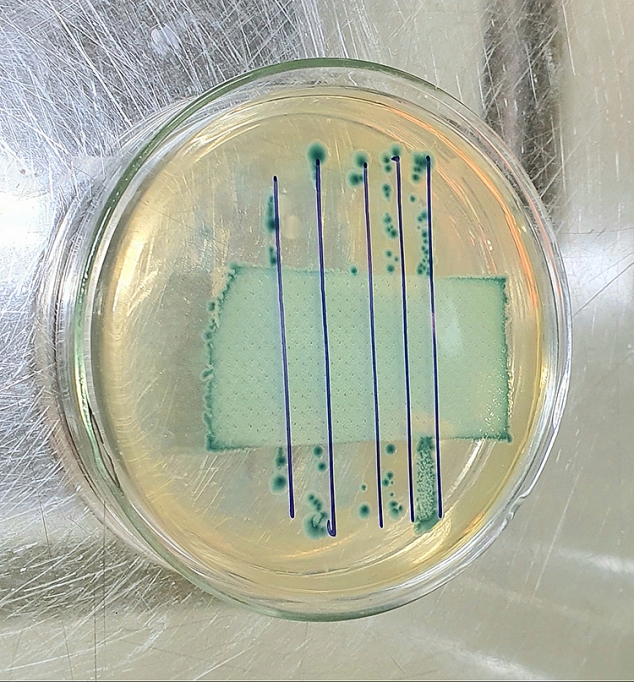

Tại cuộc họp báo chiều ngày 31/1 của Bộ Y tế, các chuyên gia khẳng định, người dân có thể dùng khẩu trang y tế thông thường hoặc dùng khẩu trang vải để phòng ngừa virus corona. Theo PGS.TS Trần Đắc Phu, nguyên Cục trưởng Cục Y tế dự phòng: Việc đeo khẩu trang có tác dụng phòng chống bệnh hô hấp rất tốt, giảm nguy cơ bị ảnh hưởng bởi ô nhiễm môi trường, khói bụi, phòng nhiều bệnh khác như cúm. Bộ Y tế cũng khuyến cáo, chỉ người chăm sóc bệnh nhân, nhân viên y tế điều trị trực tiếp, đi vào ổ dịch mới dùng khẩu trang N95 và quần áo bảo hộ lao động chuyên dụng. Người dân có thể dùng khẩu trang vải và phải giặt hằng ngày.
![]() |
| Kiểm định vải kháng khuẩn trong phòng Lab tại Trung tâm thí nghiệm dệt may |
Hiện trong sản xuất và thương mại dệt may, vải kháng khuẩn được sử dụng rộng rãi để sản xuất mặt hàng mặc lót, hàng thể thao, hàng gia dụng và quần áo bảo vệ ở những nơi có nguy cơ lây nhiễm cao như bệnh viện, khách sạn, trường học, quần áo sử dụng cho bác sĩ, nhân viên y tế và cho bệnh nhân, các trang bị như băng vết thương.
Trả lời cầu hỏi: Vậy vải kháng khuẩn được các doanh nghiệp dệt may Việt Nam sản xuất như thế nào? TS. Nguyễn Văn Thông - nguyên Viện trưởng Viện Dệt may - cho biết, phương pháp chung nhất để có được sản phẩm dệt kháng khuẩn là đưa các chất kháng khuẩn và giữ chúng bền lên (hoặc vào trong) vật liệu dệt trong suốt quá trình sử dụng. Các chất kháng khuẩn được đưa lên vải thường là những chất diệt khuẩn hoặc ức chế vi khuẩn phát triển. Hiện tại, các chất sử dụng trong sản xuất vải kháng khuẩn chủ yếu là chất diệt khuẩn.
Bên cạnh đó, chúng ta có thể đưa các chất kháng khuẩn vào dung dịch kéo sợi để tạo ra các loại xơ, sợi nhân tạo và tổng hợp có khả năng kháng khuẩn và độ bền kháng khuẩn cao. Các loại xơ sợi có tính kháng khuẩn bền có thể kể đến các loại xơ từ vixco tre, xơ sợi crabyon (chứa chitosan), và các sản phẩm sợi hóa học có chứa ion bạc, một số oxyt kim loại có đặc tính kháng khuẩn như oxyt kẽm trong sợi crystal I-COOL (talent). Ưu điểm của phương pháp này là độ bền kháng khuẩn của vải thường được duy trình trong suất quá trình sử dụng vải. Hạn chế của phương pháp này là thời gian sản xuất lâu hơn, không đáp ứng được yêu cầu tức thời của thị trường.
“Trước đây và cho đến hiện tại, trên thế giới cũng như tại Việt Nam, việc đưa các chất kháng khuẩn lên vải chủ yếu được thực hiện sau công đoạn tẩy trắng, nhuộm màu hoặc in hoa theo các cách khác nhau: ngấm ép, tráng phủ hoặc phun… Xử lý theo phương pháp này, vải thành phẩm có khả năng diệt tới 90% vi khuẩn sau 1h tiếp xúc và giảm còn 60-70% sau một số lần giặt (sau 10 hoặc 20 lần giặt tùy theo loại chất kháng khuẩn sử dụng). Ưu điểm của công nghệ này là có thể xử lý các lô hàng nhỏ, nhanh và linh hoạt trong việc sản xuất và cung ứng sản phẩm cho khách hàng, phù hợp với yêu cầu cung cấp kịp thời vải kháng khuẩn cho sản xuất khẩu trang vải”, TS. Nguyễn Văn Thông chia sẻ.
Chủng loại các chất kháng khuẩn sử dụng để sản xuất vải kháng khuẩn tại Việt Nam rất phong phú, bao gồm các chất kháng khuẩn tổng hợp và các chất kháng khuẩn tự nhiên. Hầu hết các chất kháng khuẩn tổng hợp sử dụng trên hàng dệt may đều là chất diệt khuẩn, có hoạt tính diệt khuẩn mạnh, có thể ứng dụng theo các phương pháp khác nhau, hiệu quả trên các loại xơ, sợi.
![]() |
Các chất kháng khuẩn được sử dụng nhiều trong sản xuất vải kháng khuẩn tại Việt nam có thể kể đến như Silvadur 930 FLEX antimicrobial (Dow), Ruco-Bac AGL, Guc-BAC AGP (Rudolf group), Ablusil Q-Guard (Taiwan surfactant), sanitized TH22-27 (Clariant), Agion® AM-B10G (Agion) và chế phẩm từ Chitosan.
Vậy khả năng diệt khuẩn của các loại vải này thế nào? Câu hỏi này cũng được TS. Nguyễn Văn Thông cho biết: Hiện có hai nhóm phương pháp thử để đánh giá khả năng kháng khuẩn của vật liệu dệt gồm: Các phương pháp định tính gồm AATCC TM147 và AATCC TM30 (kháng nấm) (Hiệp hội Các nhà hóa dệt và hóa màu vật liệu dệt Mỹ), ISO/DIS 20645, EN ISO 20645 và ISO 11721 và SN195 920 (921 - kháng nấm) (tiêu chuẩn Thụy Sỹ); các phương pháp định lượng gồm AATCC 100, ISO 20743, SN 195924, JIS L1902 và ASTM E 2149.
Cũng theo TS. Nguyễn Văn Thông, hiện các phương pháp định lượng được áp dụng rộng rãi hơn dù tốn thời gian và chi phí vì phải đếm số lượng vi khuẩn thực tế và xác định mức độ hoạt động diệt khuẩn/diệt nấm. Các phương pháp định lượng có thể sử dụng cho tất cả các loại vật liệu dệt và chất kháng khuẩn và có thể thực hiện các so sánh giữa các phương pháp xử lý kháng khuẩn khác nhau cũng như các mức độ xử lý khác nhau trên cùng một loại vật liệu. Các phương pháp được thừa nhận và sử dụng nhiều trong thương mại dệt may quốc tế là AATCC 100, ISO 20743 và AATCC 147.
Tại Việt Nam, hiện Trung tâm thí nghiệm dệt may thuộc Công ty CP Viện nghiên cứu Dệt may là đơn vị tại Việt Nam có khả năng thử nghiệm khả năng kháng khuẩn của vải theo tiêu chuẩn AATCC 100, ISO 20743 và AATCC 147 được công nhận phù hợp tiêu chuẩn ISO 17025: 2017 và được thừa nhận quốc tế.
Trong bối cảnh hiện tại, chất lượng vải kháng khuẩn phục vụ sản xuất khẩu trang cần đáp ứng các yêu cầu chứng nhận hợp quy theo QCVN 01/BCT: 2017 và có khả năng diệt khuẩn ≥ 90% thử nghiệm theo tiêu chuẩn AATCC 100: 2012.
Cũng tại Việt Nam, việc nghiên cứu và ứng dụng công nghệ xử lý kháng khuẩn cho vải đã được nhiều đơn vị và cá nhân quan tâm ở các quy mô khác nhau: quy mô phòng thí nghiệm và quy mô công nghiệp. Công nghệ xử lý và sản xuất vải kháng khuẩn đã được nhiều doanh nghiệp dệt may ứng dụng trong sản xuất vải theo yêu cầu của khách hàng trong nước và quốc tế. Với điều kiện thiết bị hiện tại, nhiều doanh nghiệp có đủ điều kiện để triển khai sản xuất vải kháng khuẩn.
Cần phải thấy một thực tế là sản phẩm khẩu trang có khả năng kháng khuẩn hiện chưa phải là mặt hàng chính tại các doanh nghiệp dệt may. Trước nhu cầu khẩu trang phòng chống dịch bệnh lên cao, bằng sự kết hợp giữa các doanh nghiệp dệt nhuộm và doanh nghiệp dệt may, với sự kết nối của các cơ quan Nhà nước và các cơ quan chức năng, việc sản xuất khẩu trang từ vải kháng khuẩn hoàn toàn có thể đáp ứng kịp thời yêu cầu thiết yếu và thực tế phục vụ nhân dân.
| Để giúp doanh nghiệp có thêm thông tin về công nghệ sản xuất, thử nghiệm đánh giá khả năng kháng khuẩn của vải, tư vấn công nghệ kháng khuẩn, kết nối các doanh nghiệp có nhu cầu mua vải kháng khuẩn để sản xuất khẩu trang vải và các sản phẩm dệt may, da giày có yêu cầu vải kháng khuẩn, các doanh nghiệp có thể liên hệ: Công ty CP Viện Nghiên cứu Dệt may, địa chỉ: 478 Minh Khai, phường Vĩnh Tuy, Hai Bà Trưng, Hà Nội, số điện thoại: 0912776321 (ông Lượng)/ 02438624025. |